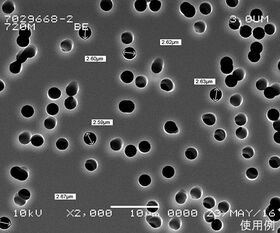

説明
【特徴】
●5~12μmの非常に薄いポリカーボネートフィルムに貫通した孔が開いている為、孔径を上回る径を持った粒子は、確実に表面に捕獲されます。
【仕様】
●材質:ポリカーボネート
●最高使用温度:140℃
●オートクレーブ:可
●滅菌:ガンマー線、EO可
●膜質:親水性
●破壊強度:0.7bar
追加情報
メーカー名:
GVS
メーカー品番:
1215612
予定納期:
注文から1~3日で発送